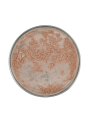
Golden Dune Beige Mica (12-60micron)

Golden Dune Beige Mica (12-60micron)
Synthetic mica pearlescent pigment with high brightness, smooth texture, and good heat resistance for premium color cosmetics.
Golden Dune Beige Mica (12-60micron) is a pearlescent pigment based on Synthetic Mica for premium-grade color cosmetics.
Synthetic Mica is a lab-created, highly pure mineral (fluorophlogopite) offering superior brightness, smoother texture, and higher heat resistance compared to natural mica. It is suitable for premium-grade color cosmetics.
It helps create a bright, clean pearlescent effect with a smooth skin feel and stable performance in pressed powders, loose powders, blush, eyeshadow, highlighter, lipstick, lip gloss, and other makeup systems.
Product Description: Synthetic Mica offers cleaner optical brightness and a more refined particle feel than conventional natural mica-based pigments. This makes it useful when a smoother, more premium shimmer profile is needed in decorative cosmetics, especially in products where payoff, spreadability, and visual clarity are important.
Usage: pressed powder, loose powder, blush, eyeshadow, highlighter, lipstick, lip gloss, and other color cosmetic products.
Mixing method:
- Disperse into oils, esters, silicones, or other suitable carriers before addition for more even distribution.
- In powder systems, blend thoroughly to achieve uniform color and pearlescent payoff.
- In emulsion or anhydrous makeup systems, add with adequate mixing to maintain smooth visual effect.
Usage rate: adjust according to target shade intensity, opacity, and shimmer effect.
Product characteristics: fine pearlescent pigment powder.
Solubility: insoluble; use by dispersion.
Storage: keep tightly closed in a cool, dry place away from moisture.
- Room (25-40C)
- 84 Months from manufacturing or testing date.
- 0.10% - 100.00%
- 0.00%
- Mix in powder
- Avoid heat above 80C
- 0.00 - 0.00
- Dispersible in oil, Dispersible in silicone
- Cream, Lotion, Clear Gel, Mask, Scrub, Liquid Soap, Bar Soap (pH >7), Bar Soap (pH <7), Eye Shadow, Brush-on
- › CI 77019
- -
| Test Name | Specification |
|---|---|
| Synthetic Fluorphlogopite | 63.0-71.0% |
| Titanium Dioxide | 23.0-28.0% |
| Iron Oxides | 5.0-9.0% |
| Tin Oxide | <1.0% |
| Particle Size (D10, μm) | 10.0-15.0 |
| Particle Size (D90, μm) | 50.0-60.0 |
| Color and Appearance (STD sample comparison) | Conforms |
| pH | 6.0-11.0 |
| Loss on Drying (%) | <1.0 |
| Oil Absorption (g/100g) | 60-90 |
| Pb | <10 |
| Hg | <1 |
| As | <1 |
| Ni | <10 |
| Ba | <50 |
| Sb | <2 |
| Cd | <1 |
| Cr | <20 |
| Co | <10 |
| Cu | <20 |
| Nd | <1 |
| Se | <1 |
| Total Aerobic Microbial Count (1) | ≤10² cfu/g |
| Total Molds and Yeasts count (2) | ≤10 cfu/g |
| Bile-Tolerant Gram Negative Bacteria | absent/g |
| Escherichia Coli | absent/g |
| Staphylococcus Aureus | absent/g |
| Pseudomonas Aeruginosa | absent/g |
| Salmonella Species | absent/10g |
| Candida Albicans | absent/g |
| Clostridia | absent/g |
Cart
No products